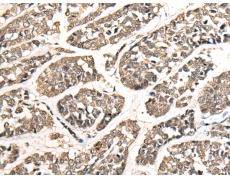
一抗

中文名稱:兔抗ZNF41多克隆抗體
|
Background: |
This gene product is a likely zinc finger family transcription factor. It contains KRAB-A and KRAB-B domains that act as transcriptional repressors in related proteins, and multiple zinc finger DNA binding motifs and finger linking regions characteristic of the Kruppel family. This gene is part of a gene cluster on chromosome Xp11.23. Several alternatively spliced transcript variants have been described, however, the full-length nature of only some of them is known. |
|
Applications: |
ELISA, IHC |
|
Name of antibody: |
ZNF41 |
|
Immunogen: |
Fusion protein of human ZNF41 |
|
Full name: |
zinc finger protein 41 |
|
Synonyms: |
MRX89 |
|
SwissProt: |
P51814 |
|
ELISA Recommended dilution: |
5000-10000 |
|
IHC positive control: |
Human esophagus cancer |
|
IHC Recommend dilution: |
25-100 |

 購(gòu)物車
購(gòu)物車 幫助
幫助
 021-54845833/15800441009
021-54845833/15800441009